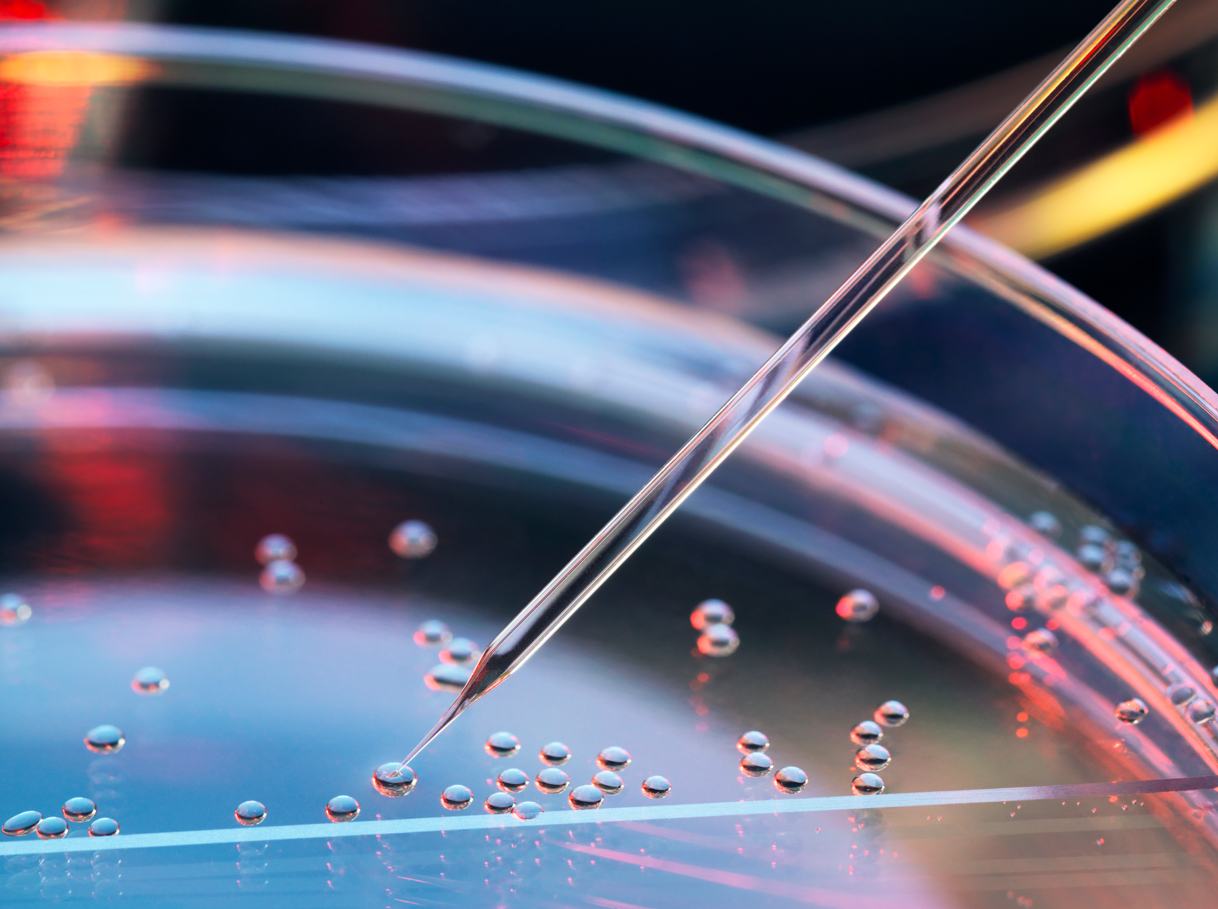
九源基因啟動招股 百惠擔任聯席賬簿管理人及聯席牽頭經辦人 - 百惠證券

九源基因啟動招股 百惠擔任聯席賬簿管理人及聯席牽頭經辦人
杭州九源基因工程股份有限公司(下稱“九源基因”),股票代碼2566.HK,於2024年11月20日至11月25日期間招股,百惠金控團隊擔任聯席賬簿管理人及聯席牽頭經辦人。此次IPO項目全球發行約4539.9萬股,招股價為每H股11.48港元至12.56港元,預計集資額最高約5.7億港元。據百惠金控了解,九源基因預計會在2024年11月28日掛牌上市。
百惠金控據悉,九源基因將通過香港資本市場平台募集資金,並投放到以下方面:加速推進在研產品的開發進程,以豐富其產品管線;進一步擴大其商業化能力,增強市場競爭力;提升生產和質量控制的能力;積極尋求業務拓展的合作機會;以及投資於技術人才的培養。通過這些戰略投資,九源基因旨在鞏固其在生物醫藥領域的領先地位,並為未來的增長奠定堅實的基礎。
據招股書資料披露,九源基因於1993年成立於浙江省,是一家專業從事生物藥品和醫療器械產品的研發、生產和銷售的中國生物制藥公司。公司專注於以下核心領域,包括骨科、代謝疾病、腫瘤及血液四大快速增長的治療領域。
百惠金控據公司的財務數據顯示,九源基因在業績方面表現良好:2021年至2023年,九源基因的營收分別為人民幣13.07億元、人民幣11.25億元和人民幣12.87億元,期內利潤分別為人民幣1.19億元、人民幣5987萬元和人民幣1.19億元。
近年來,香港IPO市場迎來越來越多的生物醫藥股上市,例如由百惠金控團隊助力IPO項目的藥師幫(9885.HK)、一脈陽光(2522.HK)及華昊中天(2563.HK)等。百惠金控分析,相對寬松的港股市場已成為眾多內地企業,尤其是醫藥公司上市募資的重要窗口。
作為本次IPO項目的聯席賬簿管理人及聯席牽頭經辦人,百惠金控團隊積極利用自身資源,全面展示九源基因的企業優勢和市場潛力,助力其在香港上市,進一步提升企業價值和競爭力。百惠金控看好九源基因將將以此次上市為契機,推動公司的研發結果及發展,從而在全球生物醫藥市場中占據更有利的競爭地位。





